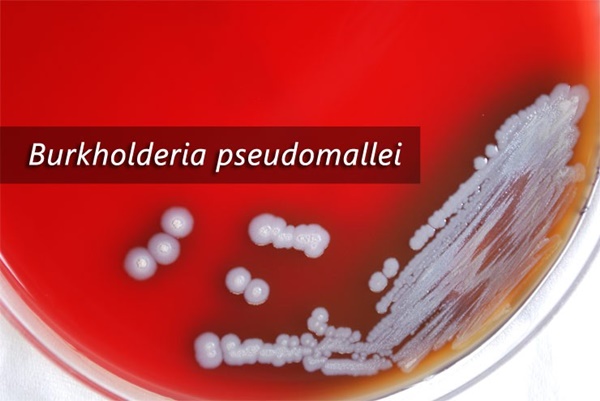

Ngay khi có thông tin về người mắc bệnh whitmore đến nỗi bị ăn mòn cánh mũi, suy đa tạng… nhiều người đã không khỏi khiếp sợ, cho rằng đây là căn bệnh hiếm gặp và cực nguy hiểm.
Xuất hiện ngày càng nhiều trường hợp bệnh nhân mắc bệnh whitmore nguy kịch
Bệnh viện Đa khoa tỉnh Hà Tĩnh mới phát hiện một trường hợp bệnh nhân mắc bệnh Whitmore. Trước khi nhập viện 1 tuần, bệnh nhân 61 tuổi bị sốt cao liên tục, ngón 2 bàn chân phải có khối áp xe sưng, nóng, chảy dịch có mùi hôi và được người nhà đưa vào điều trị tại Khoa Nội tiết - Bệnh viện đa khoa tỉnh Hà Tĩnh.

Bệnh viện Đa khoa tỉnh Hà Tĩnh mới phát hiện một trường hợp bệnh nhân mắc bệnh Whitmore.
Trong quá trình điều trị bệnh nhân có diễn biến nặng dần với dấu hiệu sốt cao, rét run, huyết áp tụt. Bác sĩ chỉ định lấy máu bệnh nhân nuôi cấy, kết quả bị whitmore, phản ứng chậm với điều trị, phải chuyển lên tuyến trên điều trị tích cực nhưng vẫn chưa khả quan.
Trước đó, Bệnh viện Bạch Mai cũng tiếp nhận trường hợp nữ bệnh nhân bị whitmore ăn mòn cánh mũi. Trước khi được chuyển tới đây, bệnh nhân được chẩn đoán bị nhiễm trùng huyết do tụ cầu nhưng tại Bệnh viện Bạch Mai, sau khi cấy máu và mủ ở vết thương cho kết quả dương tính với vi khuẩn whitmore.
Theo thống kê của Bệnh viện Bạch Mai, từ đầu năm đến nay, bệnh viện đã tiếp nhận 20 trường hợp mắc bệnh whitmore, trong đó riêng tháng 8 có 12 trường hợp, trong đó đã có 4 ca tử vong.

Whitmore – Căn bệnh đang bị lãng quên tại Việt Nam được giới chuyên gia nhìn nhận thế nào?
BS Trịnh Thị Vinh (trưởng phòng xét nghiệm vi sinh, Khoa Xét nghiệm, Bệnh viện đa khoa tỉnh Hà Tĩnh) nhận định: "So sánh với các căn nguyên gây bệnh khác, chúng tôi thấy whitmore không phải là một loại bệnh hiếm gặp như nhiều người đang suy nghĩ. Thực tế, đây là căn bệnh đang bị lãng quên tại Việt Nam".
BSCK I Nguyễn Xuân Bảo (Trưởng khoa Truyền nhiễm, Bệnh viện đa khoa tỉnh Hà Tĩnh) thì cho rằng, whitmore là bệnh truyền nhiễm cấp tính nguy hiểm do vi khuẩn Burkholderia pseudomallei gây nên. Bệnh có thể gây tử vong nhanh nếu không được chẩn đoán đúng và điều trị kịp thời. Tỷ lệ tử vong chung của các bệnh nhân nhiễm bệnh whitmore từ khoảng 40% – 60%. Đối với những trường hợp nhiễm khuẩn cấp có thể tử vong trong vòng 1 tuần kể từ khi phát bệnh.
Tỷ lệ tử vong chung của các bệnh nhân nhiễm bệnh whitmore từ khoảng 40% – 60%.
Người bệnh có cơ địa tiểu đường, bệnh phổi và bệnh thận mạn tính dễ mắc whitmore. Điều khó khăn hiện nay là bệnh whitmore có bệnh cảnh lâm sàng đa dạng phức tạp, bệnh nhân có thể nhập viện ở nhiều chuyên khoa khác nhau như truyền nhiễm, hô hấp, cơ - xương - khớp, nội tiết, da liễu, ngoại khoa… do đó có thể khiến bác sĩ chẩn đoán nhầm với các bệnh khác như viêm phổi, lao phổi, áp xe cơ, nhiễm trùng huyết do các vi khuẩn khác như tụ cầu, liên cầu…
"Cách để phát hiện được căn bệnh này là làm xét nghiệm máu, nước tiểu hoặc mủ để phân lập tìm ra vi khuẩn", BS Bảo cho hay.
Theo BS Bảo, whitmore là căn bệnh khó phát hiện, quá trình điều trị cũng hết sức khó khăn vì người bệnh phải sử dụng kháng sinh liều cao tấn công liên tục kéo dài trong ít nhất khoảng 2 tuần, sau đó tiếp tục sử dụng kháng sinh duy trì 3-6 tháng nữa. Nếu không được điều trị đúng liều, đúng phác đồ và theo dõi sát sao, bệnh dễ tái phát và sức khỏe người bệnh cứ suy kiệt dần.

Cách để phát hiện được căn bệnh này là làm xét nghiệm máu, nước tiểu hoặc mủ để phân lập tìm ra vi khuẩn.
"Dấu hiệu nghi ngờ bệnh nhân mắc bệnh whitmore thường là sốt, viêm phổi, xuất hiện ổ áp xe ở nhiều vị trí, nhiễm trùng đường tiết niệu… Những dấu hiệu này thường xuất hiện nhiều ở bệnh nhân có tiền sử tiểu đường, mắc các bệnh mạn tính liên quan đến thận hoặc phổi, người nghiện rượu, người làm việc trực tiếp, thường xuyên với đất như nông dân. Đối tượng người già rất dễ mắc vì thường có hệ miễn dịch yếu", BS Bảo cảnh báo.
TS Quế Anh Trâm (trưởng khoa Bệnh nhiệt đới, Bệnh viện Hữu nghị đa khoa Nghệ An) cho biết thêm, bệnh whitmore có nhiều biến chứng nguy hiểm. "Đôi khi chỉ là vết xước tay, xước chân ban đầu bị nhiễm trùng trên da, sau đó gặp phải các biến chứng nặng hơn như nhiễm trùng máu, áp xe, viêm phổi... Nếu không có cách phát hiện nhanh, bệnh nhân có khả năng tử vong chỉ trong vài ngày".
Do đó, khi cơ thể xuất hiện những triệu chứng trên, bạn cần hết sức cảnh giác, phải đến ngay những bệnh viện uy tín, có phòng xét nghiệm vi sinh để được khám và điều trị kịp thời, tránh những biến chứng nguy hiểm. Đối với bệnh nhân đã từng bị whitmore phải thường xuyên tái khám vì bệnh có khả năng tái phát cao, phải có sự kiên trì điều trị vì điều trị khỏi bệnh cần đến 6 tháng giống như bệnh nhân bị lao.

Whitmore có thể xâm nhập vào cơ thể đôi khi chỉ qua vết xước tay, xước chân ban đầu bị nhiễm trùng trên da, sau đó gặp phải các biến chứng nặng hơn như nhiễm trùng máu, áp xe, viêm phổi...
TS Trịnh Thành Trung (Viện Vi sinh vật và công nghệ sinh học, Đại học quốc gia Hà Nội) cũng nhận định, tỷ lệ tử vong khi mắc bệnh whitmore là 60%. "Whitmore là một bệnh truyền nhiễm rất nguy hiểm, có thể diễn tiến tối cấp và gây tử vong nhanh với tỷ lệ tử vong cao. Tuy nhiên, chúng ta hoàn toàn có thể chữa khỏi nếu phát hiện đúng bệnh và thực hiện điều trị kháng sinh theo phác đồ hướng dẫn", TS Trịnh Thành Trung phát biểu. Ông cũng bày tỏ mong muốn mọi người từ người dân đến bác sỹ hãy nâng cao ý thức cảnh giác với căn bệnh nguy hiểm này.
Giới chuyên gia nhấn mạnh, Việt Nam tuy nằm trong vùng dịch tễ của bệnh nhưng các báo cáo về bệnh whitmore còn hạn chế. Người mắc bệnh whitmore tăng nhiều vào mùa mưa, chủ yếu do tiếp xúc vết xước với đất hoặc nước nhiễm khuẩn. Vi khuẩn gây bệnh whitmore có thể sống ở tất cả mọi nơi, đặc biệt trong đất ẩm, đất canh tác nông nghiệp như đất trồng lúa nên cần hết sức cẩn trọng.
Theo Helino
